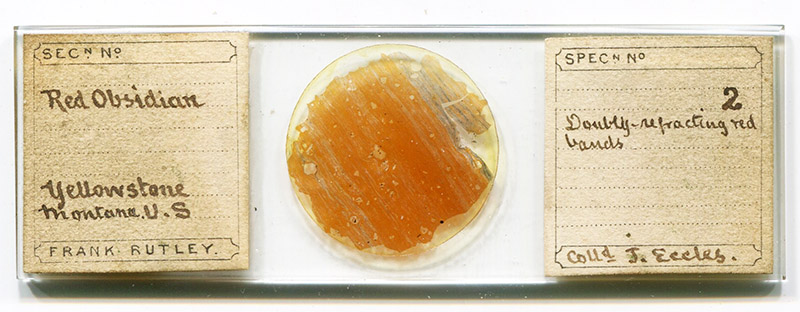

Frank Rutley, 1842 - 1904
by Brian Stevenson
last updated August, 2025
Frank Rutley was a professional geologist with the UK Geological Survey, both in the field as a collector and in the office performing analyses. He wrote numerous books and research papers on geological topics. Rutley was also instrumental in the design and production of a high quality, purpose-built petrological microscope, the first of its sort to be made in England. Rutley prepared numerous microscope slides throughout his career, most of which are now housed in museums. Occasionally, his mounts are seen in private collections.

Figure 1.
Thin-section of red obsidian mounted on a microscope slide by Frank Rutley. He wrote about this specimen in 1881, “No. 2. Yellowstone district. Obsidian. Reddish-brown or Indian-red coloured rock, with some dark brown or black streaks and mottling, opaque, except in thin sections” (see text below for his full description). The specimen was collected in 1878 by James Eccles in the Yellowstone region of Montana, USA.

Figure 2.
Magnified view of the red obsidian specimen shown in Figure 1. Rutley wrote about this specimen in 1881: “The generally parallel disposition of the bands imparts an appearance to the magnified section which very closely resembles the structure seen in a longitudinal section of wood; and this resemblance is further heightened by the deflection of the bands around small porphyritic crystals and fragments of quartz, which may be likened to little knots in wood”. Imaged with a 3.5x objective lens,C-mounted digital SLR camera, and crossed polarizing filters on a Leitz Ortholux II microscope. See also Figure 5 at the end of this essay.

Figure 3.
Frank Rutley employed the London microscope maker Thomas W. Watson (a nephew of William Watson, who had his own manufacturing and retail business) to produce a purpose-built petrological microscope that incorporated designs of Karl H.F. Rosenbusch onto an English-style instrument. The left panel is from Rutley’s 1879 “The Study of Rocks: An Elementary Text-book of Petrology”. The other two panels show a surviving Rutley-model petrological microscope that was made by Watson Brothers, the partnership that Thomas Watson formed with his brother, Arthur, in 1884 (adapted for nonprofit, educational purposes from an internet auction site).

Figure 4.
Undated photographs of Frank Rutley. Adapted for nonprofit, educational purposes from https://earthwise.bgs.ac.uk/index.php/Frank_Rutley
Frank Rutley was born in Dover, Kent, on May 14, 1842. He was the elder of two children of George and Bertha Rutley, and the only boy. Father George was a surgeon.
Frank was educated first at the private Faversham Grammar School, then at a private English school in Bonn, Germany. He attended the Royal School of Mines from 1862 until 1864, where he attended “lectures of Hofmann, Tyndall, Huxley, Ramsay, and Warington Smyth in the various branches of science taught there, though he did not complete the associateship course by devoting himself to technical work in mining or metallurgy”.
Leaving school, Rutley enlisted in the Army as an Ensign in the Royal Scots Regiment. He left as a Lieutenant in 1867.
Rutley then began as an Assistant Geologist for the Geological Survey, working in the Lake District. A colleague later wrote that Rutley’s 1870 and 1871 papers on glaciation of the Lake District, “displayed a minute knowledge of the geology of the area”.
The same colleague wrote, “It was at this time that Rutley first showed his skill as a worker with the microscope, in the study of minerals and rocks - a branch of geological inquiry which had only recently been inaugurated by the labours of Sorby, David Forbes, Allport, and a few other workers in this country. This led to his being transferred to the central office of the Geological Survey at Jermyn Street, where he not only arranged a very instructive series of specimens for the Museum of Practical Geology, but also aided the surveyors in the field by his examination and description of rock specimens sent up to town by them. To this period belong the important memoirs which he wrote for the Geological Survey upon 'The felsitic lavas of England and Wales' and 'The volcano of Brent Tor’.”
Rutley was elected as a Fellow of the Geological Society of London in 1870.
He published a popular book, Mineralogy, in 1874. This “exceedingly useful little book” went on to at least twelve editions.
Another popular book, The Study of Rocks: An Elementary Text-book of Petrology, was published in 1879. As noted above (Figure 3), this included description of a petrological microscope that was designed by Rutley and produced by the London manufacturer Thomas W. Watson. Rultey also published a two-page description of the instrument in Nature. He wrote that it is “a sound and serviceable instrument, and, after long experience of microscopes, I can confidently say that I have never seen one better suited for the work for which it is designed.”
In 1881, Rultey was awarded the Geological Society of London’s Murchison Fund award, an annual prize to researchers who are under the age of 40 and have made substantial contributions studies of geology.
Also in 1881, Rutley presented on “The microscopic characters of the vitreous rocks of Montana” to the Geological Society, with a subsequent paper. This is particularly noteworthy, as the microscope slide shown in Figure 1 was evidently one of the 8 examples of minerals that Rutley described (note that the slide bears the number “2”).
“No. 2. Yellowstone district. Obsidian. Reddish-brown or Indian-red coloured rock, with some dark brown or black streaks and mottling, opaque, except in thin sections. Bright vitreous or slightly resinous lustre, and imperfect conchoidal fracture. It is seen by transmitted light to consist of delicate bands or strings of a clear yellow or orange-colour, with here and there a few bluish-black or grey strings. The material lying between these coloured strings, which are very closely packed, is a colourless or almost colourless glass. The yellow fibres depolarize in all azimuths except those coinciding with the directions of the principal sections of the crossed Nicols. There is therefore a marked optical difference between the yellow and the colourless bands, the latter being perfectly isotropic. The generally parallel disposition of the bands imparts an appearance to the magnified section which very closely resembles the structure seen in a longitudinal section of wood; and this resemblance is further heightened by the deflection of the bands around small porphyritic crystals and fragments of quartz, which may be likened to little knots in wood. Although the greater portion of the preparation appears dark between crossed Nicols when the general direction of the bands is parallel with one or other of the Nicol-sections, still the deflected bands around the porphyritic crystals transmit a strong brownish-yellow light, because they do not, in this position, coincide with either of the Nicol-sections, so that around each brightly depolarizing porphyritic crystal there are also depolarizing fringes resembling smoothly-combed tresses of hair. Some of the porphyritic quartz-crystals have irregular creeks of glass passing into them, in some cases the yellow fibres being mixed with the included colourless glass, thus clearly showing that these quartz crystals were actually developed within the rock prior to or during its solidification. The preparation also shows numerous dark opaque granules and a few dark sections, apparently of minute octohedra, which are opaque, except at their margins, where they feebly transmit light; and this imperfect opacity seems to imply that they are not magnetite. The fine banding in this rock is a most perfect example of fluxion-structure.”
The Yellowstone specimens that Rutley described were collected by James Eccles (1838-1915) during his trip to the area in 1878. He provided an appendix to Rutley’s paper, describing the source area, “The Yellowstone National Park, within which are the head-waters of two of the great forks of the Missouri (the Yellowstone river and the Madison) and of the Snake river (one of the branches of the Columbia, comprises an area of about 3600 square miles, nearly the whole of which is covered up by volcanic rocks of great thickness. There are very few exposures of underlying sedimentary or other formations; and these are almost entirely limited to the extreme northern edge of the area. Some fifteen miles south of the southern boundary the extension of these volcanic rocks is seen to rest upon the northern spurs of the Teton range of mountains, at which point the underlying formation has been ascertained by Prof. Bradley to be of Carboniferous age. On approaching the Park from the south along the upper valley of the Snake, these volcanic rocks appear to form an irregular plateau densely covered with forest. From the point at which we first struck this plateau, as far as the Upper Geyser basin on the Firehole river (the chief branch of the Madison), is a linear distance of about twenty-five miles, but three days of hard travelling. The rocks consist entirely of varieties of obsidian and trachyte, the latter almost invariably being found in great mass under the former. The obsidian, though frequent, is somewhat irregularly distributed. It is both black and reddish brown, is occasionally columnar, and is nearly always porphyritic.”
Rutley was appointed Lecturer on Mineralogy at the Royal College of Science in 1882.
A study of Frank’s personal life illustrates the dangers of childbearing in the 1800s. He married Mary Emma Jane Adams in 1868. The pair had three children, in 1869, 1870, and 1873. Mary died in March, 1873, after giving birth to daughter Florence. Frank remarried in 1877, to Mary Ellen Richmond. She died in May, 1883, after giving birth to their fourth child, Ernest. Frank married for a third time in 1884, to Ellen Hadwin. They do not appear to have had children, and Ellen outlived Frank.
In 1898, Rutley suffered a stroke, and subsequent paralysis, that forced him to retire from his position at the Royal College. A colleague wrote, “For several years, so far as his strength permitted, he continued to work with unabated enthusiasm at petrological subjects; and until the end he never ceased to take great interest in his favourite studies.”
A further description, “He was a man who in early life was endowed with great vigour, but his habits were somewhat erratic; he burned the midnight oil far too much, toiling into the early morning when he should have slumbered, and finding it difficult in consequence to conform to the regulations of official life; but he was a genial companion, full of dry humour, and ever ready to assist others. His published work shows how assiduous and painstaking he was.”
Frank Rutley died on May 16, 1904, two days after his 62nd birthday.

Figure 5
Another view of Rutley’s thin-section preparation of obsidian from Yellowstone (Figure 1). Imaged with a 3.5x objective lens,C-mounted digital SLR camera, and crossed polarizing filters on a Leitz Ortholux II microscope.
Resources
Eccles, James (1881) On the mode of occurence of some of the volcanic rocks of Montana, U.S.A., Quarterly Journal of the Geological Society of London, pages 399-401
England census and other records, accessed through ancestry.com
Judd, J.W. (1904) Frank Rutley, The Mineralogical Magazine, pages 59-61
Rutley, Frank (1865) With reference to the Article in No. IX, On a sudden sinking of the soil in a field at Lexden in Essex, The Geological Magazine, pages 231-232
Rutley, Frank (1870) Geology of the Lake District, The Geological Magazine, pages 584-585
Rutley, Frank (1871) Glaciation of the Lake District, The Geological Magazine, page 93
Rutley, Frank (1874) Mineralogy, Thomas Murby, London
Rutley, Frank (1875) Notes on some peculiarities in the microscopic structure of felspars, Quarterly Journal of the Geological Society, pages 479-488
Rutley, Frank (1879) The Study of Rocks: An Elementary Text-book of Petrology, Longmans, Green & Co, London
Rutley, Frank (1879) An English microscope for the use of students of mineralogy and petrology, Nature, Vol. 20, pages 13-14
Rutley, Frank (1881) The microscopic characters of the vitreous rocks of Montana, Quarterly Journal of the Geological Society of London, pages 391-399, 402 (plate 2)
Woodward, H.B. (1904) Frank Rutley, The Geological Magazine, pages 333-335